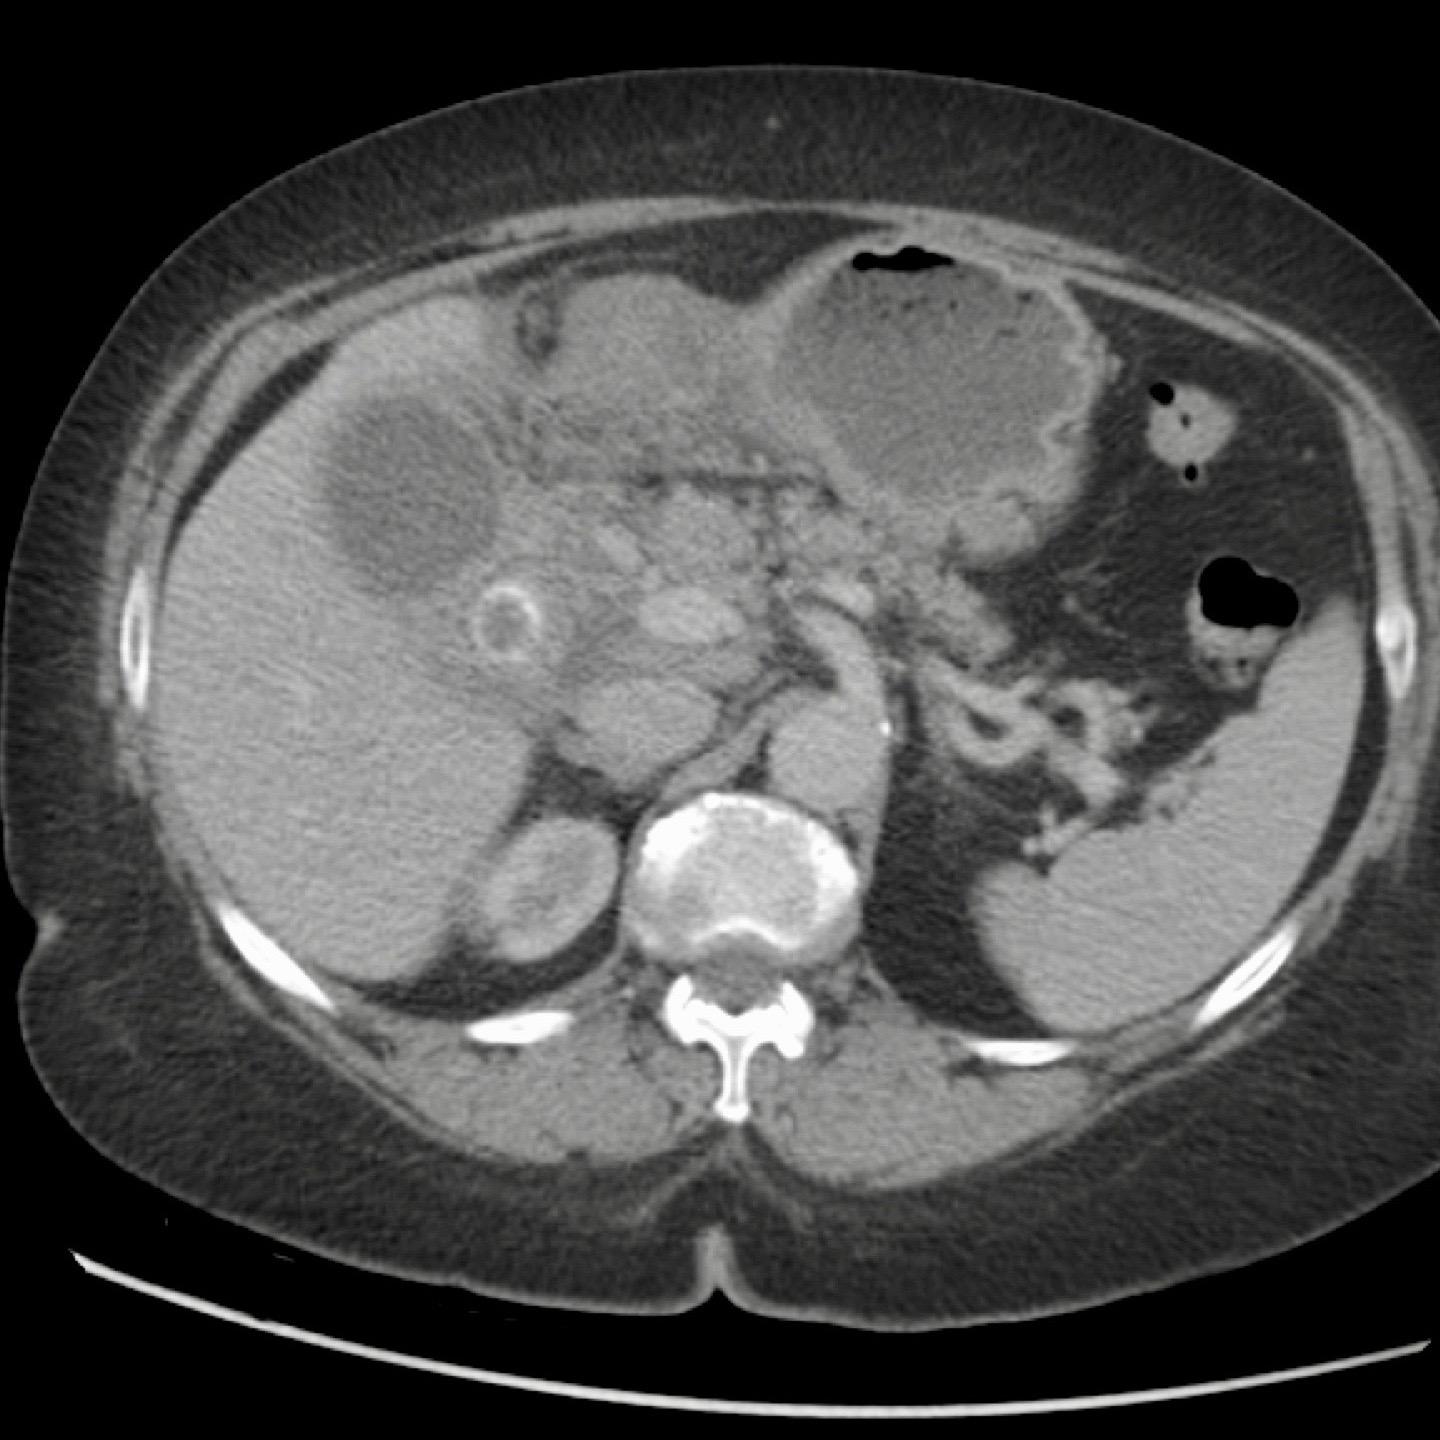
Slider image 1
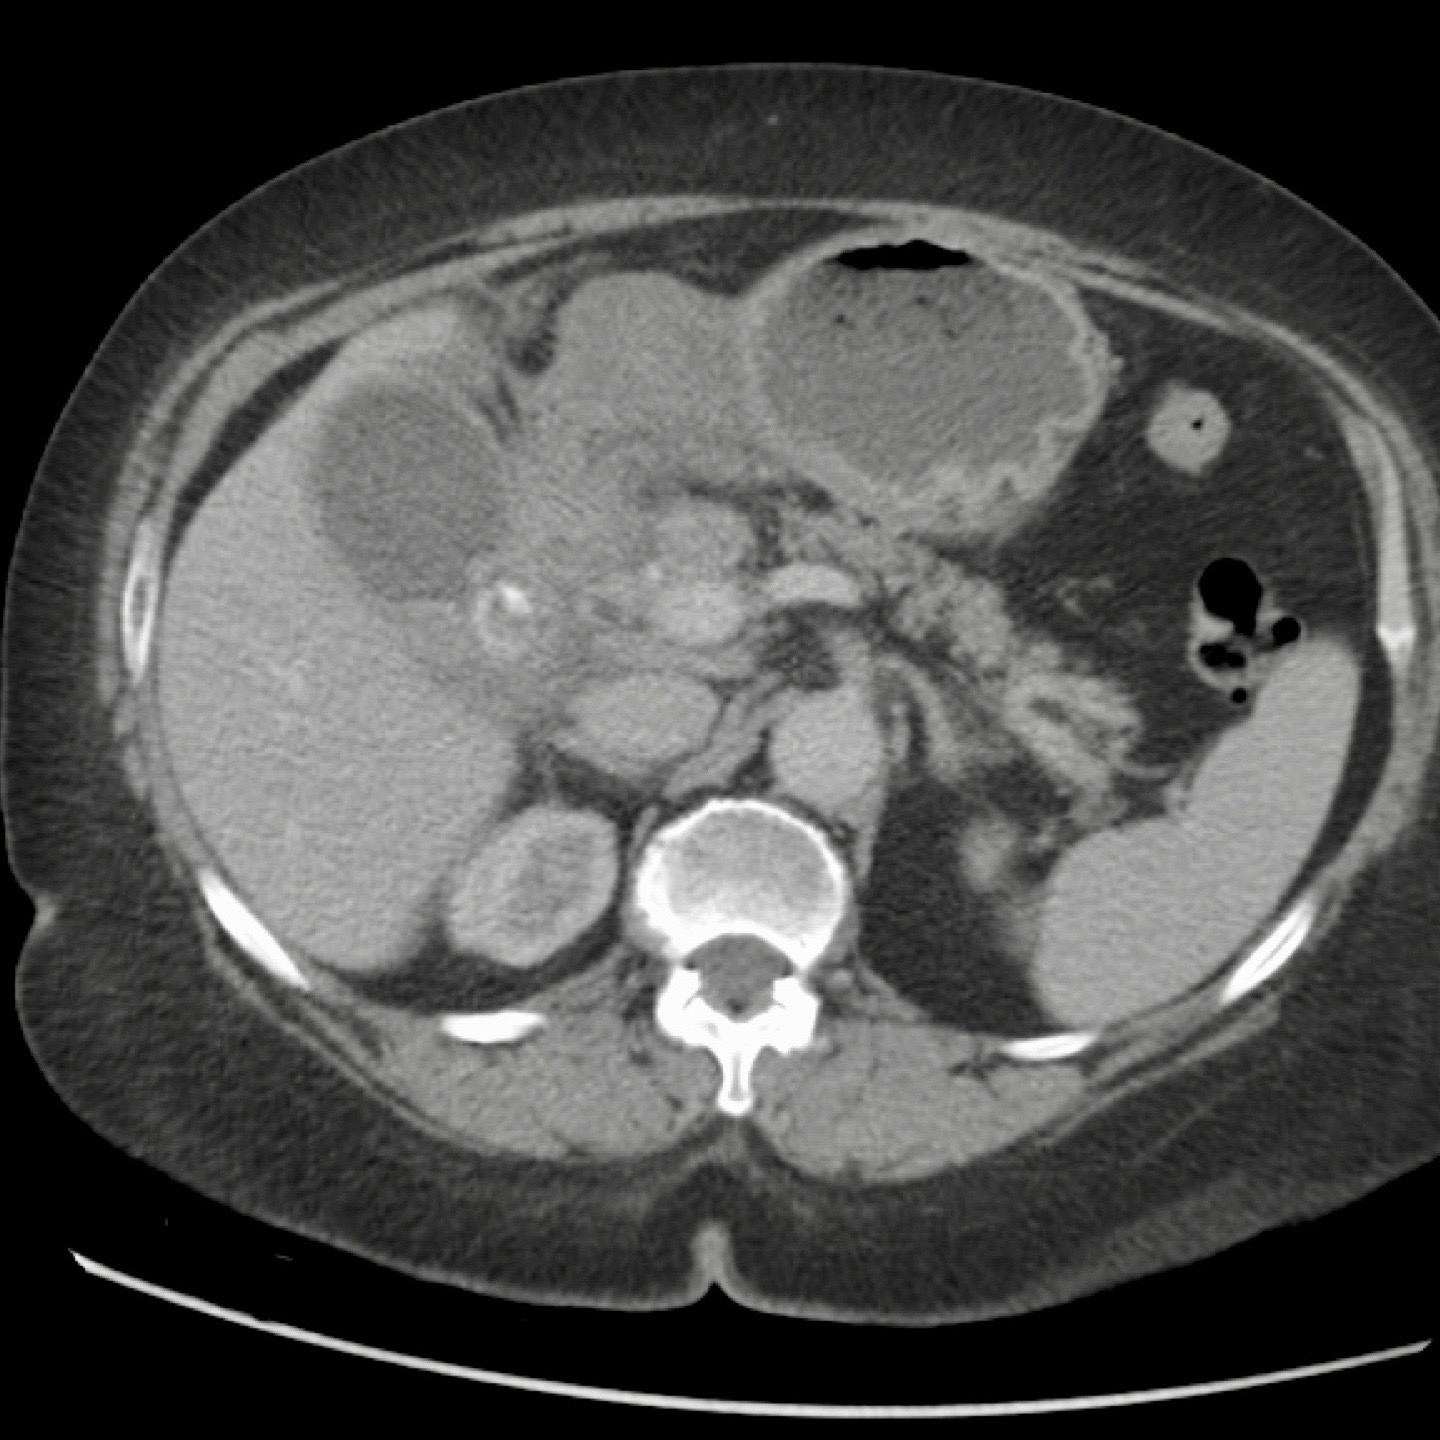
Slider image 2
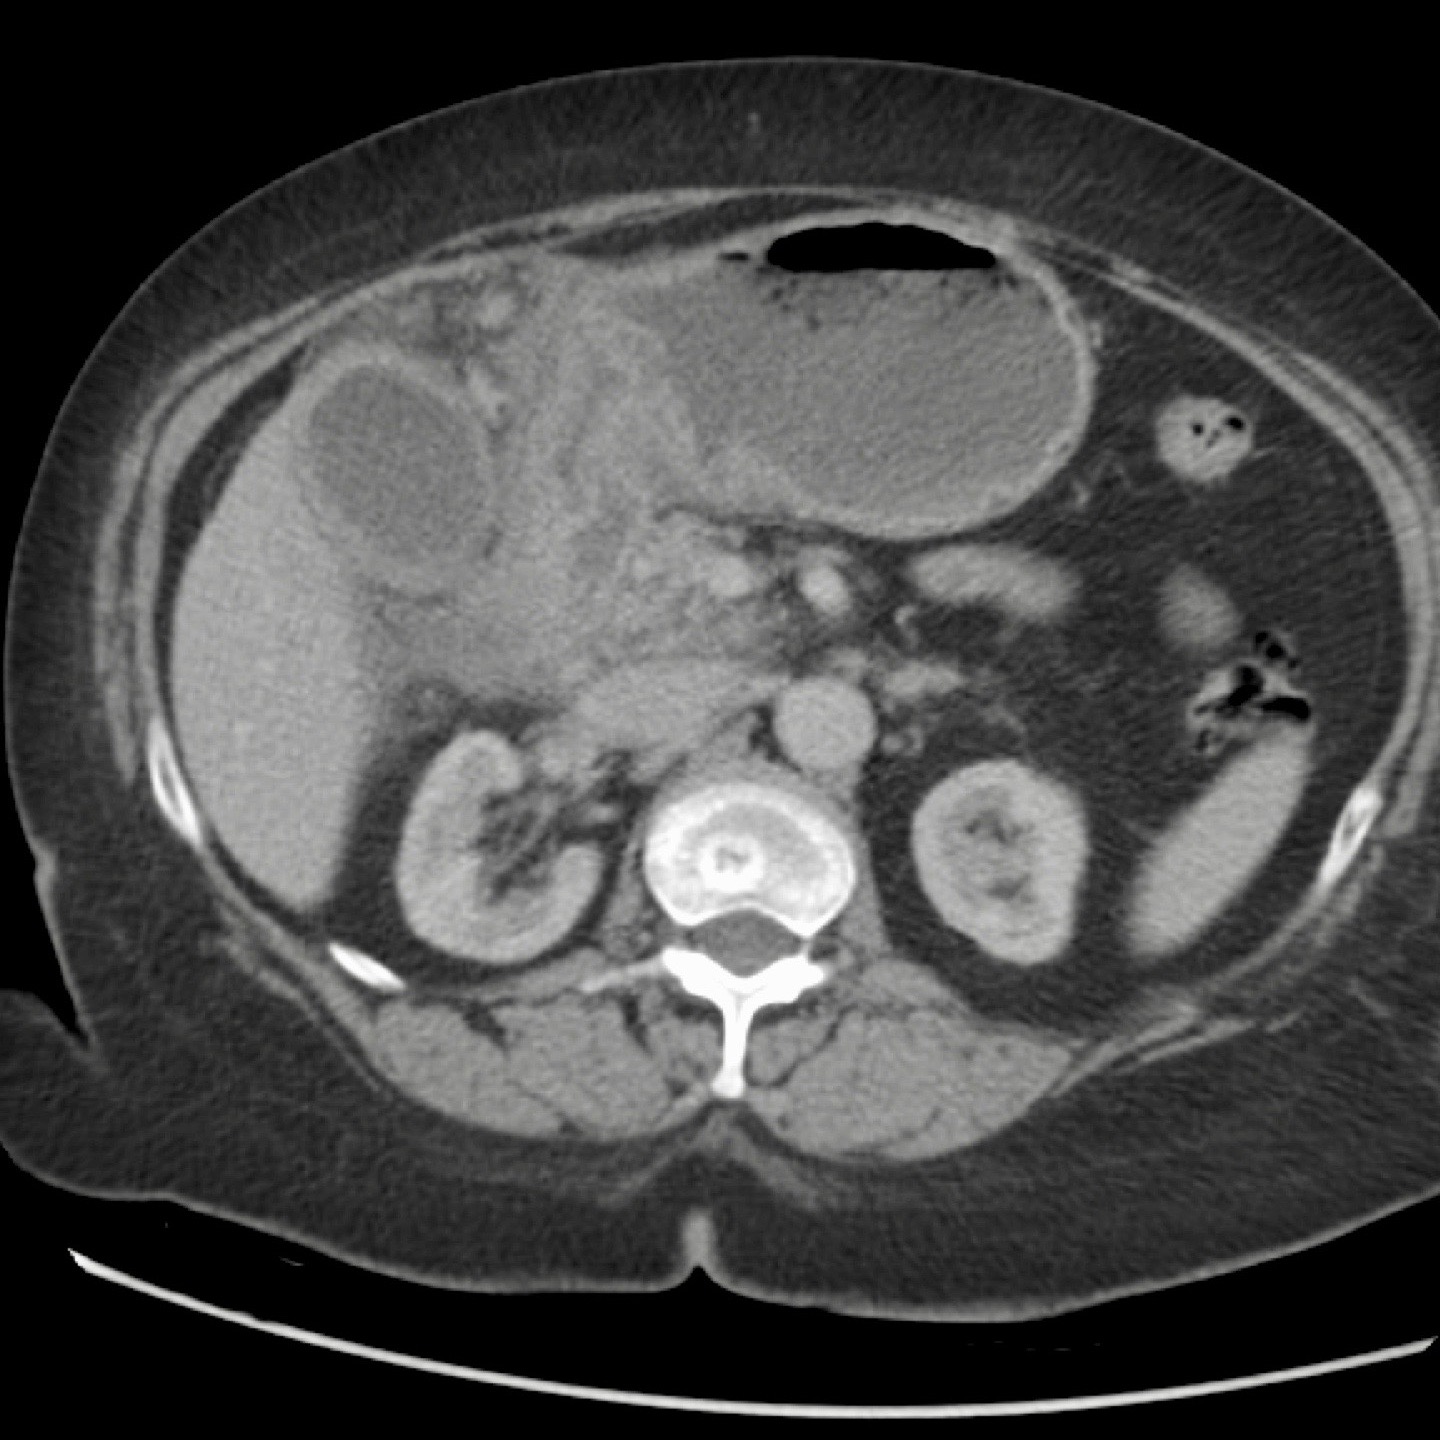
Slider image 7
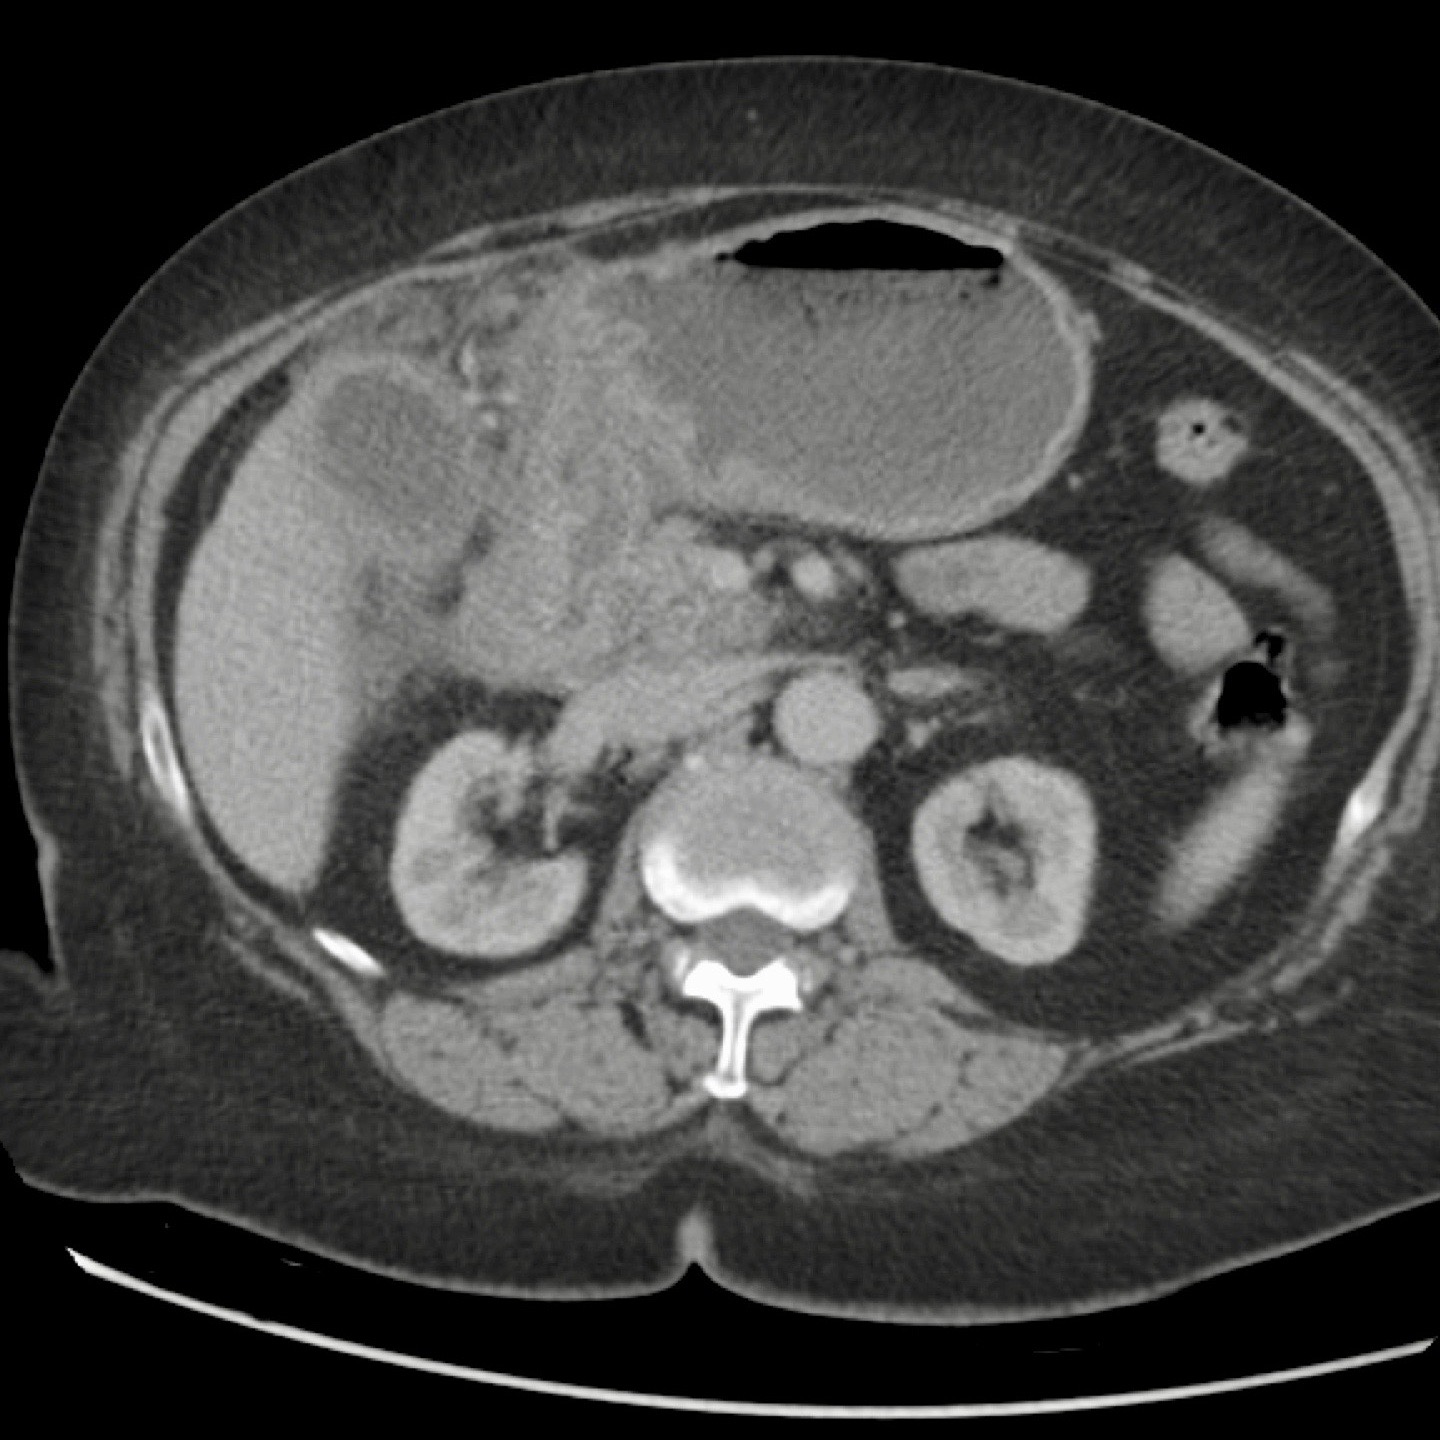
Slider image 8

Tắc túi mật
Hầu hết các sỏi mật được phát hiện qua siêu âm đều không có triệu chứng và không cần điều trị.
Tuy nhiên, khi sỏi mật gây tắc nghẽn túi mật hoặc ống mật chủ, chúng sẽ trở nên có triệu chứng.
Trong phần 2, chúng ta sẽ thảo luận về các sỏi gây tắc nghẽn đường mật.
Trong phần 1, chúng ta sẽ thảo luận về các sỏi mật gây tắc nghẽn túi mật.
Chúng ta sẽ tập trung vào:
- Cách xác định sỏi mật có triệu chứng hay không.
- Cách chẩn đoán sỏi tại cổ túi mật hoặc ống túi mật.
- Cách phát hiện các dấu hiệu gián tiếp của sỏi có triệu chứng.
- Các thể viêm túi mật cấp tính khác nhau và các biến chứng của chúng.
Để góp ý và nhận xét bổ sung: j.puylaert@gmail.com
Giới thiệu
Sỏi có triệu chứng
Sỏi mật trở nên có triệu chứng khi chúng gây tắc nghẽn túi mật hoặc ống mật chủ (OMC).
Tắc nghẽn ngắt quãng dẫn đến cơn đau quặn mật đơn thuần.
Sỏi kẹt gây tắc nghẽn túi mật dẫn đến tình trạng phình to túi mật cấp tính (hydrops cấp).
Sự tiết dịch nhầy liên tục gây tăng áp lực trong lòng túi mật, dẫn đến thiếu máu tương đối của thành túi mật.
Dưới đây là tổng quan về các diễn tiến khác nhau khi có sỏi kẹt tại cổ túi mật:
- Sỏi tự di chuyển trước khi xảy ra thiếu máu thành túi mật và không ghi nhận dày thành thứ phát.
- Sỏi tự di chuyển và sau khi áp lực trong lòng túi mật được giải phóng, xuất hiện phù nề thành do tái tưới máu thoáng qua, sau đó tự thoái lui và túi mật trở về bình thường. Hiện tượng tái tưới máu này là bằng chứng thầm lặng của một viên sỏi có triệu chứng.
- Tắc nghẽn tiếp diễn và viêm túi mật cấp phát triển.
Điều quan trọng cần nhận thức là bệnh nhân chỉ cảm thấy đau trong giai đoạn phình to túi mật cấp (hydrops).
Xét nghiệm cận lâm sàng chỉ cho thấy tăng bạch cầu, trong khi CRP vẫn trong giới hạn bình thường.
Sau khi tình trạng hydrops thoái lui, cơn đau quặn kết thúc nhưng bệnh nhân thường còn cảm giác “đau âm ỉ” trong một thời gian.

CT nghi ngờ bóc tách động mạch chủ. Phát hiện duy nhất có ý nghĩa là hai sỏi OMC, thấy rõ nhất trên chuỗi chụp không tiêm thuốc cản quang (mũi tên).
Sỏi không có triệu chứng
Tuy nhiên, phần lớn bệnh nhân có sỏi mật sẽ không gặp bất kỳ vấn đề nào liên quan đến sỏi trong suốt cuộc đời.
Do đó, sỏi mật không có triệu chứng được phát hiện tình cờ qua Siêu âm hoặc CT thực hiện vì lý do khác thường không cần điều trị.
Y văn ghi nhận rằng hơn 20% bệnh nhân được phẫu thuật cắt túi mật không thay đổi triệu chứng sau phẫu thuật, cho thấy chẩn đoán bệnh sỏi mật có triệu chứng ban đầu chưa được thực hiện chính xác.
Mặt khác, chẩn đoán bệnh sỏi mật cấp tính có thể bị bỏ sót do bác sĩ nhầm lẫn triệu chứng với một bệnh lý khác, ví dụ như bệnh tim mạch cấp tính.
Điều này lý giải tại sao khoảng 15% bệnh nhân có cơn đau quặn mật cấp ban đầu được chuyển đến khám chuyên khoa tim mạch.
Cơn đau quặn mật
Khi một sỏi mật gây tắc nghẽn túi mật hoặc ống mật chủ (CBD) từng đợt, cơn đau quặn mật sẽ xảy ra.
Các triệu chứng thường điển hình với các cơn đau dữ dội vùng thượng vị, lan ra sau lưng và sang bên phải, nhưng đôi khi cũng lan sang bên trái.
Bệnh nhân thường buồn nôn và có thể ngất xỉu vì đau.
Không hiếm trường hợp cơn đau đánh thức bệnh nhân khỏi giấc ngủ.
Trong cơn đau quặn mật, bệnh nhân thường không thể ngồi yên, có xu hướng phải di chuyển và đi lại.
Họ liên tục “cố tìm một tư thế để chịu đựng cơn đau”.
Khi sỏi không gây tắc nghẽn cổ túi mật tại thời điểm thăm khám, việc chẩn đoán bệnh sỏi mật có triệu chứng sẽ gặp khó khăn và người thăm khám có thể ấn xẹp đáy túi mật (hình).
Tuy nhiên, ở những bệnh nhân có tiền sử các cơn đau quặn điển hình, không biến chứng, không có dấu hiệu ứ mật, và được siêu âm phát hiện sỏi trong túi mật, chỉ định cắt túi mật là rõ ràng.
Mặt khác, ở những bệnh nhân có triệu chứng không điển hình, không phải lúc nào cũng có thể xác định chắc chắn liệu sỏi túi mật được phát hiện trên siêu âm có thực sự là nguyên nhân gây ra triệu chứng của bệnh nhân hay không, dẫn đến không ít trường hợp triệu chứng không thay đổi sau khi cắt túi mật.
Tuy nhiên, ở những bệnh nhân có tiền sử các cơn đau quặn điển hình, không biến chứng, không có dấu hiệu ứ mật, và được siêu âm phát hiện sỏi trong túi mật, chỉ định cắt túi mật là rõ ràng (hình).
Mặt khác, ở những bệnh nhân có triệu chứng không điển hình, không phải lúc nào cũng có thể xác định chắc chắn liệu sỏi túi mật được phát hiện trên siêu âm có thực sự là nguyên nhân gây ra triệu chứng của bệnh nhân hay không, dẫn đến không ít trường hợp triệu chứng không thay đổi sau khi cắt túi mật.
Bệnh nhân này có cơn đau quặn điển hình vài ngày trước khi thăm khám.
Ở tư thế đứng, không có sỏi gây tắc nghẽn tại cổ túi mật.
Thậm chí ống túi mật cũng được quan sát thấy với đường đi điển hình song song với ống mật chủ.
Trong trường hợp sỏi ống mật chủ gây tắc nghẽn, người thăm khám vẫn có thể ấn xẹp đáy túi mật, nhưng sẽ có các kết quả xét nghiệm điển hình với các chỉ số chức năng gan tăng cao.
Giãn đường mật sẽ xuất hiện trong thời gian rất ngắn và túi mật có thể bị giãn.
Tuy nhiên, áp lực trong lòng ống mật thấp hơn nhiều so với trường hợp tắc nghẽn đơn thuần của túi mật (hình).
Siêu âm trong cơn đau cấp tính có thể rất hữu ích.
Những bệnh nhân được siêu âm trong cơn đau quặn mật cấp tính, tại thời điểm đó – hầu như luôn luôn – sẽ biểu hiện hoặc là túi mật căng phồng (hydrops) hoặc là giãn đường mật.
Tuy nhiên, các dấu hiệu siêu âm này có thể biến mất nhanh chóng khi tình trạng tắc nghẽn được giải phóng, dù là tự nhiên hay do thuốc giãn cơ trơn, thường được dùng tại phòng cấp cứu.
Phình To Túi Mật Cấp Tính (Acute Hydrops)
Dấu hiệu phình to túi mật (Hydrops sign)
Tắc nghẽn túi mật kéo dài dẫn đến tình trạng phình to túi mật do niêm mạc túi mật tiếp tục sản xuất chất nhầy.
Dấu hiệu phình to túi mật được kiểm tra bằng cách ấn đè có kiểm soát lên vùng túi mật.
Dấu hiệu phình to túi mật được coi là dương tính khi túi mật trong lúc ấn đè “phồng lên” về phía thành bụng và duy trì hình dạng tròn (hình).
Dấu hiệu này được quan sát rõ nhất ở thì thở ra, khi các cơ thành bụng giãn ra.
Hình ảnh dưới đây cho thấy túi mật phình to vẫn duy trì hình dạng tròn trong khi ấn đè.
Nếu tình trạng tắc nghẽn kéo dài đủ lâu, áp lực trong lòng túi mật tăng cao có thể dẫn đến thiếu máu cục bộ tạm thời của thành túi mật.
Các dấu hiệu siêu âm của phình to túi mật cấp tính do sỏi kẹt gây tắc nghẽn túi mật được trình bày trong bảng.
Dấu hiệu túi mật không xẹp khi ấn đè và hình ảnh trực tiếp của sỏi kẹt tại cổ túi mật hoặc ống túi mật là những dấu hiệu có giá trị nhất (****).
Hình ảnh siêu âm của một bệnh nhân bị phình to túi mật cấp tính, được khảo sát trên mặt phẳng dọc và mặt phẳng ngang.
Sỏi gây tắc nghẽn đang ở trạng thái kẹt (mũi tên).
Lưu ý rằng khi ấn đè, túi mật phình to phồng lên về phía thành bụng (đầu mũi tên), cho thấy áp lực trong lòng túi mật tăng cao.
Tuy nhiên, không phải lúc nào cũng có thể quan sát dấu hiệu phình to túi mật một cách đáng tin cậy, đặc biệt khi túi mật nằm cao dưới cung sườn phải.
Ngoài ra, sỏi kẹt có thể không thể hiển thị được ở những bệnh nhân có thể trạng lớn, do vị trí sâu, cách xa đầu dò.
Không hiếm gặp trường hợp phình to túi mật được phát hiện trên CT scan (hình), nhưng siêu âm bổ sung thường rất hữu ích trong những trường hợp này.
Hình ảnh của một bệnh nhân được nghi ngờ lâm sàng là thủng dạ dày.
CT cho thấy một số sỏi trong túi mật có hình dạng tròn.
Siêu âm bổ sung xác nhận rõ ràng tình trạng phình to túi mật (đầu mũi tên).
Ngay cả trong trường hợp có nhu mô gan xen giữa thành bụng và túi mật, vẫn có thể chứng minh được dấu hiệu “phình to túi mật gián tiếp”.
Hình bên trái cho thấy túi mật duy trì hình dạng tròn, cả trước và trong khi ấn đè, đồng thời phồng lên vào nhu mô gan mềm xen kẽ và thành bụng.
Tương tự, sự vắng mặt của dấu hiệu phình to túi mật cũng có thể được chứng minh, ngay cả khi có nhu mô gan xen giữa, vốn mềm mại khi ấn đè (hình bên phải).
Cách phát hiện sỏi kẹt
Ở bệnh nhân này, khám siêu âm ở tư thế nằm nghiêng không thể xác định được sỏi gây tắc nghẽn do sự hiện diện của nhiều viên sỏi.
Nếu siêu âm ở tư thế đứng cho thấy tất cả các viên sỏi di động đã di chuyển xuống đáy túi mật, bệnh nhân được yêu cầu nằm xuống trở lại, ngay lập tức xoay sang bên trái.
Bằng cách này, các viên sỏi sẽ ở lại vùng đáy túi mật, giúp quan sát rõ hơn cổ túi mật và ống túi mật (hình).
Tất cả các viên sỏi đã di chuyển về phía đáy túi mật, ngoại trừ viên sỏi kẹt (mũi tên).
Có hình ảnh dày thành túi mật, gợi ý viêm túi mật đang tiến triển (CRP là 110).
Lưu ý rằng trong trường hợp mật đặc, nhớt, các viên sỏi có thể thay đổi vị trí rất chậm, đôi khi mất vài phút để di chuyển xuống điểm thấp nhất.
Vì lý do này, chúng tôi luôn yêu cầu bệnh nhân nghi ngờ sỏi túi mật ngồi hoặc đứng trong khi chờ đợi khám siêu âm.
Dưới đây là hai ví dụ về sỏi kẹt được phát hiện trong cơn đau quặn mật ở các bệnh nhân khác nhau.
Ở tư thế nằm ngửa, một viên sỏi (mũi tên) được phát hiện tại cổ túi mật.
Sau khi đứng dậy, cúi người và đi lại, viên sỏi (mũi tên) không di chuyển xuống, do đó phải là sỏi kẹt.
Sỏi trong ống túi mật đôi khi không thể hiển thị được trên mặt phẳng siêu âm theo trục dọc của túi mật.
Hình ảnh của một bệnh nhân bị phình to túi mật cấp tính do sỏi kẹt.
Sỏi kẹt không thể hiển thị được trên trục dọc của túi mật, do vị trí nằm ở phía trong của ống túi mật (mũi tên).
Đường kính lớn
Dấu hiệu thứ ba là đường kính ngang của túi mật lớn.
Đây không phải là dấu hiệu đáng tin cậy, vì đường kính túi mật có biên độ dao động rộng.
Một túi mật 2,5 cm có thể đang phình to và một túi mật có đường kính 5 cm có thể hoàn toàn bình thường (hình).
Do đó, tính không xẹp khi ấn đè và sự duy trì hình dạng tròn trong khi ấn đè vẫn là các dấu hiệu siêu âm đặc trưng của phình to túi mật.
Dấu hiệu Murphy trên siêu âm (US-Murphy-sign)
Cuối cùng, một dấu hiệu của phình to túi mật cấp tính là đau khu trú khi ấn đầu dò siêu âm lên vùng đáy túi mật, được gọi là dấu hiệu Murphy trên siêu âm.
Mặc dù thường gặp, dấu hiệu này không phải lúc nào cũng đáng tin cậy.
Đặc biệt, bệnh nhân cao tuổi bị viêm túi mật cấp thường gặp khó khăn trong việc xác định chính xác vùng đau tối đa.
Ngoài ra, nếu một bệnh lý khác như loét tá tràng, viêm tụy cấp hoặc viêm ruột thừa cấp gây ra đau vùng hạ sườn phải, dấu hiệu Murphy trên siêu âm có thể dương tính giả do túi mật nằm gần kề các cơ quan này.
Dày thành túi mật thứ phát có thể làm tăng thêm sự nhầm lẫn trong chẩn đoán.
Siêu âm thực hiện sau cơn đau quặn mật
Dấu hiệu chứng nhân thầm lặng
Điều có thể gây ra nhầm lẫn chẩn đoán đáng kể là thực tế rằng – trong thực hành hàng ngày – hầu hết các lần siêu âm ở bệnh nhân nghi ngờ sỏi túi mật có triệu chứng đều được thực hiện sau khi các triệu chứng đã thuyên giảm, với khoảng thời gian dao động từ vài giờ đến vài tuần.
Bệnh nhân cũng có thể đã được điều trị bằng thuốc giảm co thắt, khiến co thắt cơ giảm và mật có thể lưu thông trở lại, làm thay đổi hình ảnh siêu âm vốn có thể trở nên không điển hình và thậm chí gây nhầm lẫn.
Có những dấu hiệu chứng nhân thầm lặng cho thấy bệnh nhân đã từng có sỏi gây tắc nghẽn kèm phù nề túi mật (bảng).

Theo dõi 100 bệnh nhân nhập cấp cứu với phù nề túi mật cấp tính được điều trị bằng thuốc giảm co thắt và không phẫu thuật ngay. Trong số đó, 15 bệnh nhân tiến triển thành viêm túi mật cấp. 25 bệnh nhân có sỏi vẫn còn tại chỗ nhưng mật có thể lưu thông và phù nề biến mất. 60 bệnh nhân sỏi bị bong ra và túi mật trở về bình thường, đôi khi có giai đoạn phù nề tái tưới máu.
Diễn tiến tự nhiên của cơn đau quặn mật do sỏi gây tắc nghẽn cổ túi mật có thể theo nhiều hướng khác nhau.
Trong cơn đau quặn, sỏi bị kẹt tại cổ túi mật gây phù nề cấp tính.
Sự sản xuất liên tục dịch nhầy gây tăng áp lực trong lòng túi mật, dẫn đến thiếu máu cục bộ thành túi mật.
- Sỏi có thể bị bong ra, giải phóng áp lực trong lòng túi mật, tiếp theo là phù nề tái tưới máu thành túi mật, và sau đó túi mật có thể trở về bình thường.
- Sỏi bong ra trước khi xảy ra thiếu máu cục bộ thành túi mật và không thấy dày thành thứ phát.
- Sỏi vẫn còn kẹt nhưng cho phép mật lưu thông qua. Có phù nề tái tưới máu nhưng phù nề túi mật đã biến mất. Cuối cùng túi mật có thể trở về bình thường.

Siêu âm thực hiện 5 giờ sau cơn đau. Có cả phù nề tái tưới máu và tăng sinh mạch thành túi mật. Sỏi gây tắc nghẽn (mũi tên) vẫn còn thấy ở cổ túi mật, nhưng không có phù nề túi mật.
Phù nề tái tưới máu
Điều quan trọng cần nhận thức là bệnh nhân chỉ cảm thấy đau trong giai đoạn phù nề túi mật.
Xét nghiệm chỉ cho thấy tăng bạch cầu và CRP vẫn bình thường.
Sớm sau đó, áp lực trong lòng túi mật sẽ tăng cao đến mức có thể gây thiếu máu cục bộ tương đối ở thành túi mật bị căng giãn mỏng.
Nếu sỏi bị bong ra hoặc bằng cách nào đó lại cho phép mật lưu thông qua ống túi mật – có thể xảy ra tự phát hoặc do điều trị thuốc giảm co thắt – phù nề thành túi mật có thể phát triển rất nhanh (hình).
Phù nề này biến mất trong vòng 12-48 giờ và được gọi là phù nề tái tưới máu, thứ phát sau giai đoạn thiếu máu cục bộ.
Đôi khi cũng có thể phát hiện tăng sinh mạch thứ phát bằng siêu âm Doppler (hình).
Sau khi phù nề túi mật biến mất, cơn đau quặn kết thúc nhưng bệnh nhân thường còn cảm giác “đau âm ỉ” trong một thời gian.
Hình ảnh của một phụ nữ trẻ bị cơn đau quặn mật kéo dài 8 giờ.
Siêu âm cho thấy sỏi bị kẹt và phù nề túi mật.
Bệnh nhân đi bộ trong một giờ và siêu âm được thực hiện lại.
Sỏi đã bong ra, và phù nề tái tưới máu xuất hiện như những dấu hiệu chứng nhân thầm lặng của cơn đau quặn.
CRP vẫn bình thường.
Khi phù nề túi mật đã biến mất, bệnh nhân không còn đau quặn nữa.
Tuy nhiên bệnh nhân thường có cảm giác “đau âm ỉ” mơ hồ ở vùng thượng vị như thể ai đó đã “đấm vào bụng họ”.
Rõ ràng, điều thiết yếu là phải tích hợp bệnh sử của bệnh nhân, dữ liệu xét nghiệm và các phát hiện siêu âm vào báo cáo cuối cùng của lần khám siêu âm.
Vào ngày 0, có phù nề túi mật cấp tính do sỏi bị kẹt.
Một ngày sau, bệnh nhân không còn triệu chứng.
Sỏi vẫn còn tại chỗ, nhưng rõ ràng cho phép mật lưu thông qua ống túi mật, vì phù nề đã biến mất.
Phù nề tái tưới máu và bùn mật là những dấu hiệu chứng nhân thầm lặng của cơn đau trước đó.
CRP vẫn bình thường.
Dấu hiệu chứng nhân thầm lặng của cơn đau trước đó.
Siêu âm thực hiện 24 giờ sau cơn đau quặn cho thấy túi mật co nhỏ với nhiều sỏi nhỏ ở bệnh nhân chưa ăn.
Bảy ngày sau, túi mật giãn trở lại (được quan sát ở bệnh nhân đang nhịn ăn).
Dấu hiệu chứng nhân thầm lặng của cơn đau quặn mật ở sáu bệnh nhân khác nhau.
Siêu âm được thực hiện 6-12 giờ sau cơn đau.
Tất cả bệnh nhân đều không có triệu chứng tại thời điểm siêu âm.
Tất nhiên, không phải tất cả bệnh nhân đều may mắn khi cơn đau quặn mật tự thuyên giảm.
Trong số tất cả bệnh nhân nhập viện vì cơn đau quặn mật, một tỷ lệ nhỏ (10-15%) tiến triển thành viêm túi mật cấp.
Viêm Túi Mật Cấp
Nếu sỏi tiếp tục gây tắc nghẽn cổ túi mật hoặc ống túi mật, tình trạng nhiễm khuẩn của dịch mật và chất nhầy ứ đọng có thể chuyển từ phình nước túi mật cấp thành viêm túi mật cấp.
Do đây là một quá trình diễn tiến từ từ, các dấu hiệu siêu âm của viêm túi mật cấp cũng xuất hiện dần dần và chồng lên các dấu hiệu của phình nước túi mật cấp.
Bảng này trình bày các dấu hiệu siêu âm của viêm túi mật cấp chồng lên các dấu hiệu của phình nước túi mật cấp.
Các dấu hiệu siêu âm bổ sung của viêm túi mật bao gồm:
- Thành túi mật dày, thường có cấu trúc phân lớp
- Xuất hiện bùn mật như một dấu hiệu của tình trạng ứ đọng kéo dài
- Tăng sinh mạch máu thành túi mật
- Cuối cùng là tình trạng viêm mỡ xung quanh đáy túi mật, đại diện cho mạc nối lớn di chuyển đến vị trí có nguy cơ thủng sắp xảy ra
Đây là hình ảnh của một bệnh nhân viêm túi mật cấp giai đoạn sớm.
Lưu ý sỏi gây tắc nghẽn (mũi tên), thành túi mật dày và túi mật phình ra phía thành bụng khi ấn, cho thấy áp lực trong lòng túi mật cao.
CRP là 110, xác nhận chẩn đoán viêm túi mật cấp.
Viêm túi mật giai đoạn tiến triển với mỡ viêm (dấu hoa thị) xung quanh đáy túi mật.
Đây là hình ảnh mạc nối lớn di chuyển đến vị trí túi mật để bao bọc ngăn ngừa thủng có thể xảy ra.
Tuy nhiên, các dấu hiệu siêu âm bổ sung này không phải lúc nào cũng đáng tin cậy.
- Bùn mật có thể là kết quả của tình trạng ứ đọng mạn tính do nhịn ăn
- Dày thành túi mật có nhiều nguyên nhân khác ngoài viêm túi mật cấp (hình).
Đây là hình ảnh của một phụ nữ trẻ bệnh nặng với đau bụng lan tỏa và CRP 430.
Siêu âm cho thấy thành túi mật dày phù nề rõ rệt, lòng túi mật nhỏ và không chứa sỏi.
CT phát hiện viêm thận thùy (dấu hoa thị) là nguyên nhân gây triệu chứng và CRP cao của bệnh nhân.
Dày thành túi mật là thứ phát do tình trạng viêm nhiễm khuẩn.
Sau khi điều trị kháng sinh, túi mật và thận trở về bình thường hoàn toàn.
Đây là hình ảnh của một bệnh nhân cao tuổi (79 tuổi) với đau hạ sườn phải cấp tính.
Túi mật lớn, tuy nhiên không phình nước (đầu mũi tên) với sỏi di động và dày thành phù nề.
Xét nghiệm cho thấy CRP 3 và amylase huyết thanh 985.
Chẩn đoán: viêm tụy cấp do sỏi mật với dày thành túi mật thứ phát.
Bệnh nhân béo phì với đau thượng vị cấp tính.
Siêu âm cho thấy sỏi túi mật và dày thành, gợi ý viêm túi mật cấp.
CT thực hiện tiếp theo đã phát hiện bản chất thực sự của các triệu chứng: viêm tụy cấp do sỏi mật với dày thành túi mật thứ phát.
Đây là hình ảnh của một bệnh nhân với mệt mỏi, đau hạ sườn phải và rối loạn chức năng gan nặng.
Siêu âm cho thấy túi mật nhỏ với dày thành phân lớp và hạch bạch huyết quanh cuống gan to.
Chẩn đoán: viêm gan A cấp.
Phân biệt Phình Nước Túi Mật – Viêm Túi Mật Cấp
Quan trọng hơn các dấu hiệu siêu âm bổ sung trong việc phân biệt phình nước túi mật với viêm túi mật là các dấu hiệu lâm sàng và kết quả xét nghiệm: sốt và các thông số nhiễm trùng tăng cao.
Cần nhấn mạnh rằng đặc biệt ở người cao tuổi, quá trình tiến triển từ phình nước túi mật cấp sang viêm túi mật cấp thường âm thầm và thường không có biểu hiện lâm sàng rõ ràng.
Cơn đau thường ít dữ dội hơn nhiều so với cơn đau quặn mật ban đầu và thường không có sốt.
Điều này nhấn mạnh vai trò quan trọng của việc theo dõi CRP lặp lại.
Sự tăng CRP – nói chung – thường xuất hiện trước các triệu chứng lâm sàng.
Nếu bệnh nhân đến khám muộn, túi mật có thể biểu hiện những thay đổi hình thái học đáng kể.
Điều có thể gây nhầm lẫn là trong viêm túi mật giai đoạn tiến triển, dấu hiệu phình nước túi mật trên siêu âm có thể kém nổi bật hơn, do thành túi mật bị tổn thương không còn khả năng sản xuất chất nhầy và áp lực trong lòng túi mật đã giảm.
Hình ảnh cho thấy viêm túi mật cấp kéo dài.
Lưu ý vùng mỡ viêm và xơ hóa rộng (dấu hoa thị) và túi mật tương đối nhỏ, có thể ép xẹp một phần.
Điều này phản ánh lòng túi mật chứa đầy mủ, trong đó niêm mạc bị tổn thương không còn khả năng sản xuất chất nhầy dưới áp lực.
Dẫn lưu cho thấy mủ.
CT trong viêm túi mật cấp
CT có thể rất hữu ích trong các trường hợp siêu âm không cho kết quả chẩn đoán.
Đây là hình ảnh của một bệnh nhân béo phì với đau hạ sườn phải cấp tính trong 6 giờ. CRP 2.
Siêu âm cho thấy túi mật lớn có bùn mật, không quan sát thấy sỏi.
Việc ấn vào túi mật không đáng tin cậy do vị trí cao dưới cung sườn phải.
Không có bất thường siêu âm nào khác.
CT thực hiện cùng ngày cho thấy túi mật lớn với chỉ những thay đổi quanh túi mật kín đáo và không có nguyên nhân nào khác giải thích cho các triệu chứng.
Ngày hôm sau CRP là 105 và CT không tiêm thuốc cản quang lặp lại cho thấy quầng mờ xung quanh túi mật.
Phẫu thuật tiếp theo xác nhận viêm túi mật cấp giai đoạn sớm do sỏi nhỏ trong ống túi mật.
Các thể đặc biệt của viêm túi mật

Viêm túi mật khí thũng. Siêu âm cho thấy khí ở đáy túi mật (đầu mũi tên). CT xác nhận có khí cả trong lòng và trong thành túi mật.
Viêm túi mật khí thũng
Thể đặc biệt của viêm túi mật này thường gặp – nhưng không phải luôn luôn – ở bệnh nhân đái tháo đường cao tuổi và có các đặc điểm điển hình trên siêu âm và CT (hình).
Do sự hiện diện của khí cho thấy hoại tử thành túi mật, phẫu thuật cắt túi mật cấp cứu thường được khuyến cáo; tuy nhiên, dẫn lưu qua da là một phương án thay thế hiệu quả, vì phẫu thuật thường tiềm ẩn nhiều nguy cơ cao ở những bệnh nhân đái tháo đường vốn đã có tình trạng toàn thân suy kiệt nặng nề.
Các hình ảnh này thuộc về một bệnh nhân không mắc đái tháo đường, có biểu hiện đau dữ dội vùng hạ sườn phải, CRP 190 và bạch cầu 19.
Siêu âm ghi nhận hình ảnh bất thường của túi mật với cặn lắng tăng âm và các phản xạ sáng trong thành.
CT cho thấy viêm túi mật khí thũng kèm theo khí tự do trong khoang phúc mạc.
Phẫu thuật cắt túi mật kinh điển xác nhận viêm túi mật hoại tử có nhiễm bẩn phúc mạc.

Viêm túi mật xuất huyết. Siêu âm chỉ cho thấy một khối giống cặn lắng. CT cho thấy máu tăng tỷ trọng trong lòng túi mật và thành túi mật không đều. Phẫu thuật cắt túi mật rất khó khăn về mặt kỹ thuật.
Viêm túi mật xuất huyết
Viêm túi mật xuất huyết là thể hiếm gặp, xảy ra khi hoại tử thành túi mật dẫn đến chảy máu trong lòng túi mật.
Thể này gặp nhiều hơn ở bệnh nhân đang điều trị bằng thuốc kháng đông.
Siêu âm thường không đặc hiệu nhưng có thể cho thấy một khối lớn dạng cặn lắng và thành túi mật không đều.
CT cho thấy các khối tăng tỷ trọng, không suy giảm tỷ trọng trong lòng túi mật (hình).
Do xuất huyết là hậu quả của hoại tử thiếu máu cục bộ thành túi mật, phương pháp dẫn lưu qua da không được ưu tiên trong trường hợp này, mặc dù phẫu thuật cắt túi mật cũng có thể gặp nhiều khó khăn.
Đây là một trường hợp viêm túi mật xuất huyết khác ở bệnh nhân đang dùng salicylate.
CRP là 150.
Phẫu thuật cắt túi mật nội soi cấp cứu được thực hiện ngay.
Tình trạng phình to túi mật (hydrops) được xác nhận và chọc hút trong mổ cho thấy máu.
Phẫu thuật có biến chứng là khối máu tụ lớn sau mổ.
Viêm túi mật u hạt vàng
Đây là thể lành tính hiếm gặp nhưng đã được ghi nhận rõ ràng của viêm túi mật mạn tính kéo dài.
Bệnh có thể là hậu quả của nhiều đợt viêm phá hủy do sự hiện diện của sỏi.
Điều quan trọng là không được chẩn đoán nhầm thực thể này với bệnh lý ác tính.
Các hình ảnh này thuộc về một bệnh nhân nữ 82 tuổi, thức dậy lúc 4 giờ sáng với cơn đau dữ dội vùng thượng vị.
Kết quả xét nghiệm lúc nhập viện (8 giờ sau khi đau khởi phát) trong giới hạn bình thường.
Siêu âm cho thấy túi mật lớn nhưng không phình to (non-hydropic) với một sỏi nhỏ.
Không phát hiện sỏi gây tắc nghẽn.
Có một ít dịch tự do, khi chọc hút xác định là dịch mật.
CT được thực hiện nhưng không cung cấp thêm thông tin.
Phẫu thuật cắt túi mật nội soi phát hiện thủng tự do với 150 ml dịch mật trong ổ bụng.
Một trường hợp viêm túi mật thủng tự do khác.
Túi mật đã xẹp có lòng tương đối nhỏ và thành dày, phù nề, không đều.
Có dịch tự do trong phúc mạc quanh tử cung, được xác định là dịch mật qua chọc hút dưới hướng dẫn siêu âm.
Bệnh nhân nặng với đau hạ sườn phải kéo dài 4 ngày, CRP 450 và bạch cầu 14.
CT cho thấy thủng khu trú tại đáy túi mật với một ổ dịch không rõ ranh giới dưới thùy gan trái.
Phẫu thuật cắt túi mật mở cấp cứu xác nhận viêm túi mật thủng với nhiễm bẩn mủ nặng nề khoang phúc mạc.
Nếu không được phẫu thuật kịp thời, thủng tự do có thể dẫn đến hình thành áp xe ở vị trí xa, thường có vị trí và hình thái khác với các áp xe quanh túi mật trong viêm túi mật có biến chứng (hình).
Có áp xe quanh túi mật cũng như áp xe quanh gan ở xa trong viêm túi mật thủng.
Bệnh nhân được điều trị kháng sinh và chỉ dẫn lưu túi mật đơn thuần.
Áp xe trong gan kề cận túi mật trong viêm túi mật cấp, quan sát thấy trên cả siêu âm và CT.
Dẫn lưu túi mật qua da được thực hiện.
Áp xe tự dẫn lưu vào trong lòng túi mật.
Viêm túi mật giả ác tính
Viêm túi mật cấp đôi khi không được nhận diện trên lâm sàng, đặc biệt ở người cao tuổi, và có thể được điều trị bằng kháng sinh nhiều lần.
Điều này có thể làm giảm nhẹ và thay đổi quá trình viêm bình thường, dẫn đến các hình ảnh bất thường trên siêu âm và CT.
Trong những trường hợp như vậy, chẩn đoán ác tính túi mật không hiếm khi được đặt ra, có thể dẫn đến quyết định phẫu thuật lớn không cần thiết.
Cần lưu ý rằng ung thư túi mật ở các nước phương Tây rất hiếm gặp, thường không còn khả năng phẫu thuật triệt căn tại thời điểm phát hiện và có tiên lượng xấu.
Sự kết hợp giữa tiền sử lâm sàng, hình ảnh siêu âm và CT, cùng với theo dõi diễn tiến theo thời gian, có thể giúp tránh được các phẫu thuật lớn không cần thiết.
Viêm túi mật không sỏi
Viêm túi mật không sỏi là một thực thể bệnh lý dễ gây nhầm lẫn.
Viêm túi mật không sỏi thực sự, không do tắc nghẽn là cực kỳ hiếm gặp và là hậu quả của hoại tử thiếu máu cục bộ nguyên phát thành túi mật do một đợt giảm lưu lượng máu, tương tự như thiếu máu cục bộ mạc treo không do tắc nghẽn (NOMI) dẫn đến nhồi máu ruột non.
Thể này thường gặp ở bệnh nhân cao tuổi có bệnh lý nền suy kiệt hoặc sau chấn thương nặng.
Điều trị là phẫu thuật cắt túi mật cấp cứu.
Hầu hết bệnh nhân được chẩn đoán “viêm túi mật không sỏi” thực chất là những bệnh nhân bị phình to túi mật cấp tính (hydrops) hoặc viêm túi mật mà không tìm thấy sỏi trên siêu âm, CT, cũng như trong quá trình phẫu thuật hay trên mẫu bệnh phẩm giải phẫu bệnh.
Tuy nhiên, khi siêu âm xác định rõ ràng tình trạng phình to túi mật ở một bệnh nhân, rõ ràng phải có một dạng tắc nghẽn lòng ống nào đó, có thể do một sỏi rất nhỏ hoặc cặn lắng kết hợp với ống túi mật hẹp.
Do có nguồn gốc tắc nghẽn, các trường hợp này có nguy cơ biến chứng tương đương viêm túi mật cấp do sỏi và do đó cần được điều trị theo cùng một phác đồ.
Một bẫy chẩn đoán gây nhầm lẫn và thường gặp khác là hình ảnh túi mật lớn chứa đầy cặn lắng với thành dày, thường gặp ở bệnh nhân trong khoa Hồi sức tích cực (ICU).
Trong trường hợp CRP tăng cao, tình trạng này thường bị chẩn đoán nhầm và điều trị sai như viêm túi mật không sỏi.
Để tránh bẫy chẩn đoán này, điều cần thiết là kiểm tra khả năng ép xẹp của đáy túi mật trên siêu âm và thực hiện CT để phát hiện các nguyên nhân thay thế có thể giải thích cho các triệu chứng và tình trạng CRP tăng cao.
Hình thành đường rò
Viêm túi mật cấp có thể biến chứng thủng.
Hầu hết các trường hợp viêm túi mật thủng tiến triển chậm và vị trí thủng được bao bọc lại tạo thành áp-xe khu trú.
Thủng tự do trong viêm túi mật cấp khá hiếm gặp (như đã đề cập trước đó).
Viêm túi mật không được chẩn đoán hoặc không được điều trị cũng có thể dẫn đến hình thành đường rò vào tá tràng.
Đây là một biến chứng không thường gặp, nhưng khi xảy ra, hầu hết các trường hợp sỏi sẽ di chuyển vào ruột non, nơi sỏi bị kẹt lại và gây ra tắc ruột do sỏi mật.
Trong các trường hợp hiếm gặp của rò tá tràng, một viên sỏi mật lớn có thể bị “kẹt” tại đường rò vào tá tràng.
Do mô viêm và mô xơ thứ phát, tình trạng này có thể dẫn đến hẹp và tắc nghẽn.
Tình huống đặc biệt này được gọi là “hội chứng Bouveret” với biểu hiện lâm sàng chính là tắc nghẽn đường ra dạ dày.
Tắc ruột do sỏi mật
Khi không được điều trị, viêm túi mật cấp có thể dẫn đến các biến chứng mới.
Dịch mủ trong túi mật bao gồm cả sỏi mật có thể thoát ra tá tràng hoặc đôi khi vào đại tràng.
Tình trạng này thường xảy ra ở bệnh nhân cao tuổi, những người mà viêm túi mật thường không được chẩn đoán và/hoặc không được điều trị.
Thông thường liên quan đến một viên sỏi lớn, theo kinh điển bị kẹt tại van hồi manh tràng, nhưng thực tế trong hầu hết các trường hợp sỏi gây tắc nghẽn ruột non ở vị trí cao hơn tại hồi tràng hoặc thậm chí hỗng tràng.
Trong hầu hết các trường hợp, chẩn đoán dễ dàng hơn nhiều khi sử dụng CT so với siêu âm.
Phát video.
Dấu hiệu quan trọng là hơi trong túi mật.
Phát video.
Dấu hiệu quan trọng là hơi trong túi mật.
Cuộn qua các hình ảnh (trên Mac dùng hai ngón tay).
Đây là hình ảnh điển hình của tắc ruột do sỏi mật.
Lưu ý mức độ khó khăn khi phát hiện viên sỏi không vôi hóa.
Hội chứng Bouveret
Trong các trường hợp hiếm gặp của rò tá tràng, một viên sỏi mật lớn có thể bị “kẹt” trong quá trình rò kéo dài.
Do mô viêm và mô xơ thứ phát, tình trạng này có thể dẫn đến hẹp và tắc nghẽn tá tràng.
Tình huống đặc biệt này được gọi là “hội chứng Bouveret” với biểu hiện lâm sàng chính là tắc nghẽn đường ra dạ dày (hình).
Mặc dù hiếm gặp, việc chẩn đoán chính xác là vô cùng quan trọng, vì cắt túi mật rất nguy hiểm và cần tránh thực hiện.
Nếu không thể lấy sỏi qua nội soi, giải pháp tốt nhất là phẫu thuật nối vị tràng (gastrojejunostomy).
Đây là bệnh nhân có tình trạng ứ đọng dạ dày từng đợt và CRP thấp.
Cuộn qua các hình ảnh.
Các dấu hiệu hình ảnh là gì?
Một viên sỏi lớn bị “kẹt” trong đường rò từ túi mật biến dạng đến tá tràng.
Dày thành tá tràng thứ phát (đầu mũi tên) cùng mô viêm và mô xơ xung quanh gây ra tình trạng ứ đọng dạ dày từng đợt kèm nôn mửa.
Hình ảnh của một bệnh nhân nữ cao tuổi, nhập viện vì ứ đọng dạ dày và nôn mửa.
CRP là 55, nhưng được ghi nhận là 160 vài ngày trước đó.
Siêu âm cho thấy một viên sỏi lớn trong túi mật chứa đầy chất lắng cặn, thành túi mật không đều.
Dạ dày giãn to và có dày thành tá tràng đáng kể (đầu mũi tên) kèm viêm xung quanh (dấu hoa thị).
Nội soi dạ dày được thực hiện do nghi ngờ ác tính, nhưng sinh thiết chỉ cho thấy hình ảnh viêm.
Tiếp tục xem CT.
CT xác nhận chẩn đoán hội chứng Bouveret.
Dẫn lưu túi mật qua da đã giải quyết các triệu chứng ứ đọng dạ dày.
Một năm sau, viên sỏi dường như đã tự di chuyển vào lòng tá tràng, và bệnh nhân phát triển tắc ruột do sỏi mật điển hình, được phẫu thuật thành công.